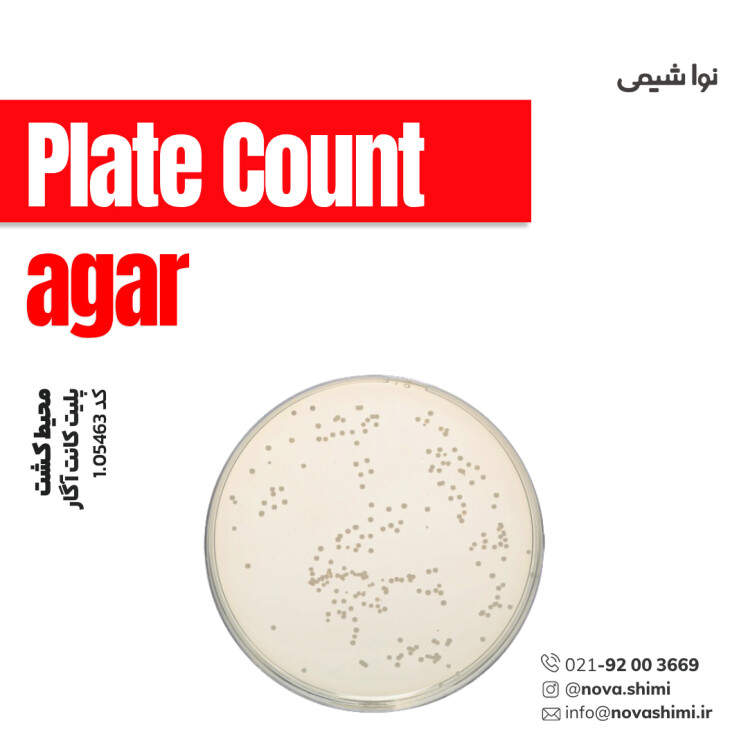
محیط کشت پلیت کانت آگار (Plate Count agar)
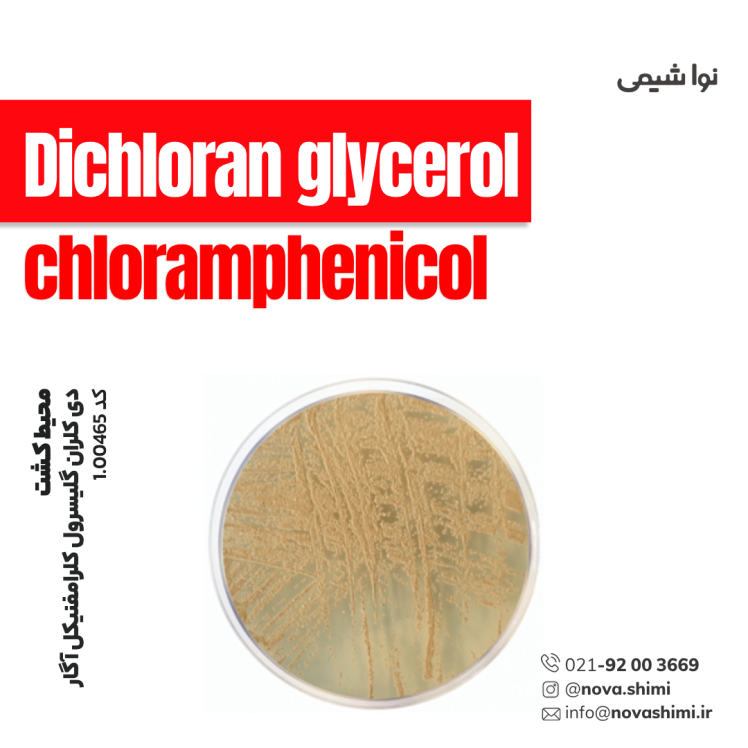
محیط کشت DG 18 آگار مرک (Dichloran glycerol chloramphenicol) agar (base))
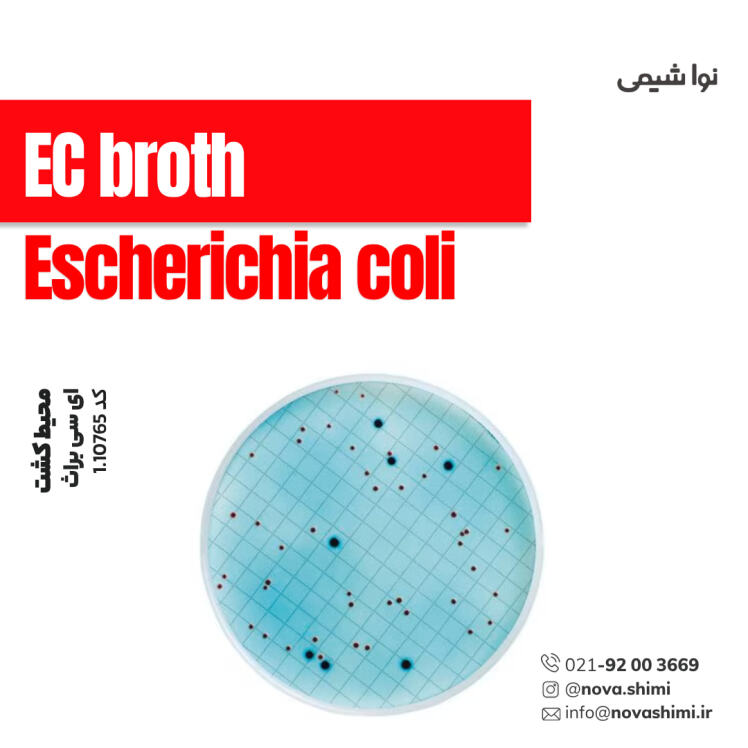
محیط کشت EC Broth مرک (EC (Escherichia coli) broth)

محیط کشت BGB broth مرک (Brilliant-Green Bile Lactose Broth)
مشخصات فنی محیط کشت BGB broth:
1. برند: Merck Millipore
2. کاربرد: تشخیص و شمارش باکتریهای کولفرم
3. فرم فیزیکی: گرانول(granular)
4. حجم بسته: ۵۰۰ گرم و 5 کیلوگرم
محیط کشت BGB broth چیست؟
برلیانت گرین بایل لاکتوز براث یک محیط کشت انتخابی برای تشخیص و شمارش باکتریهای کولفرم است که با نمکهای صفراوی و رنگ سبز درخشان رشد باکتریهای غیررودهای را مهار میکند. نُـواشیمی، به عنوان یکی از تامین کنندگان مواد آزمایشگاهی و محیط کشت برند مرک و سیگما آلدریچ، آماده ارائه خدمات فروش محیط کشت BGB broth مرک کد 1.05454 به شما عزیزان خواهد بود. برای دریافت اطلاعات فنی و استعلام قیمت محیط کشت برلیانت گرین بایل لاکتوز براث مرک، از طریق شماره 02192003669 با کارشناسان فروش نُـوا شیمی تماس حاصل فرمایید.
برای آشنایی بیشتر با ویژگیها و مشخصات محصول، میتوانید با کلیک روی هر عنوان، به توضیحات تکمیلی در زیرعنوانهای مربوطه دسترسی پیدا کنید.
مشخصات محصول (Product Specifications)
مشخصات فنی محیط کشت BGB broth مرک (Product Specifications)
در جدول زیر میتوانید مشخصات فنی محیط کشت برلیانت گرین بایل لاکتوز براث مرک را مشاهده کنید.
عنوان | توضیحات |
|---|---|
نام محصول | Brilliant-Green Bile Lactose Broth (BGB broth) |
کد محصول | 1.05454 |
برند / تولیدکننده | Millipore – Merck (سری GranuCult® prime) |
کیفیت | Quality Level 200 |
استانداردها | ISO 4831، ISO 4832، APHA، FDA-BAM |
شکل ظاهری | گرانول سبز رنگ |
فرم | Granular (گرانولار) |
حالت استریلیتی | غیر استریل (non-sterile) |
بستهبندی | 500 g و 5 kg |
رنگ | سبز |
pH | حدود 7.2 (در 30°C، غلظت 40 g/L پس از اتوکلاو) |
حلالیت | 40 g/L |
چگالی ظاهری | 560 kg/m³ |
شرایط نگهداری | خشک، درب بسته، 15–25°C |
روشها / تکنیک مناسب | Microbiological culture (Suitable) |
محدوده کاربرد | انتخابی برای E. coli و کلیفرمهای مدفوعی |
مکانیسم انتخابپذیری | وجود Brilliant Green + Bile برای مهار باکتریهای گرممثبت |
منبع کربن | لاکتوز (با تولید گاز توسط کلنیهای کولیآئروژنز) |
انطباق با رسانههای پیشتأیید | تأیید نتایج مثبت Lauryl Sulfate Broth و VRBA agar |
برای مشاهده اطلاعات کامل محصول در سایت مرک و جزئیات کاربردی آن، بر روی BGB broth کلیک کنید. شرکت نُـوا شیمی، تأمینکننده انواع محیط کشت برندهای معتبر مانند مرک و سیگما آلدریچ است و امکان خرید آسان و مطمئن این محصولات آزمایشگاهی را برای شما فراهم میکند.
خرید محیط کشت BGB broth مرک (GranuCult® prime BGB broth)
خرید محیط کشت BGB broth مرک (GranuCult® prime Brilliant-Green Bile Lactose Broth) کد 1.05454
محیط کشت BGB broth یک محیط کشت گرانولار و انتخابی است که با بهرهگیری از رنگ بریلیانتگرین و نمکهای صفراوی، رشد باکتریهای گرممثبت و غیرکوليفرم را مهار کرده و بستر مناسبی برای تشخیص و تأیید کلیفرمها و باکتریهای مدفوعی مانند E. coli فراهم میکند؛ این محیط طبق استانداردهای ISO 4831، ISO 4832، APHA و FDA-BAM، برای آزمونهای MPN، تأیید نتایج BRILA و کنترل کیفی مواد غذایی، آب و خوراک دام بهکار میرود.
کمپانی مِرک (MERCK)
شرکت مرک (Merck KGaA) یکی از قدیمیترین و معتبرترین کمپانیهای علمی و فناوری در جهان است که در سال 1668 در آلمان تأسیس شد و امروزه بهعنوان پیشگام جهانی در حوزههای مواد شیمیایی آزمایشگاهی، بیوتکنولوژی و داروسازی شناخته میشود. بخش مواد آزمایشگاهی مرک، طیف گستردهای از مواد شیمیایی با گریدهای مختلف از جمله آنالیتیکال، ACS، HPLC، و Suprapur® را ارائه میدهد که برای تحقیقات علمی، کنترل کیفیت صنعتی، و مصارف آموزشی کاربرد دارند.
شرکت نُـوا شیمی، تامین کننده مواد آزمایشگاهی محیط کشت
شرکت نُـوا شیمی، با سابقهای درخشان در تامین مواد آزمایشگاهی، استاندارد ها و تجهیزات آزمایشگاه، با دسترسی گسترده به محصولات برندهای معتبر داخلی و بینالمللی، تامین نیازهای صنایع، آزمایشگاههای تحقیقاتی و داروسازی را با رویکردی مدرن و دقیق دنبال میکند. در صورت نیاز به استعلام قیمت محیط کشت برلیانت گرین بایل لاکتوز براث مرک کد 1.05454 یا سایر مواد آزمایشگاهی، استاندارد و رفرنسهای آزمایشگاهی کارشناسان ما از طریق خط ویژه 02192003669 آماده پاسخگویی و ارائه مشاوره تخصصی به شما خواهند بود.
آنالیز و کیفیت (Analysis Note)
ویژگیهای آنالیزی و کیفیت (Analysis Note)
Appearance (ظاهر فیزیکی): گرانولهای یکنواخت، سبز
Color (رنگ): سبز
pH (30°C, 40 g/L after autoclaving): حدود 7.2
Form (فرم فیزیکی): پودر گرانولار با انحلالپذیری 40 g/L
Selectivity (انتخابپذیری): مهارکننده باکتریهای گرم مثبت توسط Brilliant Green و bile
Carbon Source (منبع کربن): لاکتوز؛ تخمیر منجر به تولید گاز
Growth Response (پاسخ رشد): رشد و گازدهی قوی در کلیفرمها و E. coli، مهار سایر باکتریها
Application (کاربرد): تأیید، غنیسازی و شمارش کلیفرمها و E. coli
Storage Condition (شرایط نگهداری): محیط خشک، ظرف کاملاً بسته، دمای 15–25°C
جدول راهنمای ویژگیهای آنالیزی محیط کشت GranuCult® prime BGB broth
ویژگی | توضیحات | تحلیل و اهمیت |
|---|---|---|
Appearance (ظاهر فیزیکی) | گرانولهای یکنواخت، سبز | یکنواختی و رنگ مشخص نشاندهنده کیفیت بالای تولید و کنترل دقیق مواد خام است. |
Color (رنگ) | سبز | حضور Brilliant Green بهعنوان مهارکننده رشد باکتریهای غیرمدفوعی را تأیید میکند. |
pH (30°C, 40 g/L) | حدود 7.2 | pH مناسب برای تخمیر لاکتوز توسط کلیفرمها و تولید گاز در تستهای تأییدی. |
Form (فرم) | گرانولار، انحلالپذیری 40 g/L | دانهبندی گرانولار غبار را کم کرده و آمادهسازی محیط را سریع و ایمن میکند. |
Selectivity (انتخابپذیری) | مهار باکتریهای گرم مثبت | انتخابپذیری بالا باعث افزایش دقت تستهای تأییدی ISO و FDA میشود. |
Carbon Source (منبع کربن) | لاکتوز | تخمیر لاکتوز همراه با تولید گاز، شاخص تشخیصی اصلی کلیفرمها است. |
Growth Response | تولید گاز در کلیفرمها و E. coli | تولید گاز معیار کلیدی تست MPN در کنترل کیفیت آب و غذا است. |
Application | غنیسازی، شمارش و تأیید کلیفرمها | استانداردترین محیط تأییدی پس از Lauryl Sulfate Broth و VRBL agar. |
Storage Condition | 15–25°C، محیط خشک | جلوگیری از رطوبت از کلوخه شدن و کاهش قدرت انتخابپذیری جلوگیری میکند. |
کاربردهای محیط کشت EC Broth
مهمترین کاربردهای محیط کشت BGB broth:
در ادامه، کاربردهای محیط کشت BGB broth مرک را مطالعه خواهیم نمود:
1. تکثیر انتخابی E. coli و کولایهای رودهای: این محیط کشت با دارا بودن brilliant green و صفرا رشد باکتریهای گرم مثبت و سایر باکتریهای غیرهدف را مهار کرده و رشد انتخابی باکتریهای گروه کولای، به ویژه E. coli را تشویق میکند.
2. شمارش میکروبی کل و گروه کولای رودهای: محیط برای تعیین تعداد کلنیهای کولای و E. coli در نمونههای غذایی، آب آشامیدنی، خوراک دام و سایر مواد مناسب است.
3. تأیید مثبت بودن نمونهها پس از تست پیشتستی: معمولاً پس از آزمایش اولیه با محیطهای کمتر انتخابی مانند Lauryl Sulfate Broth، نمونههایی که واکنش مثبت نشان دادهاند، برای تأیید به BGB broth منتقل میشوند.
4. کنترل کیفیت مواد غذایی و خوراک دام: استفاده از این محیط به تولیدکنندگان کمک میکند تا سطح آلودگی میکروبی محصولات خود را بررسی و تضمین کنند که مقدار E. coli یا کولایهای رودهای از حد مجاز فراتر نرفته است.
5. تأیید نتایج پس از کشت در محیطهای دیگر: BGB broth بهعنوان محیط ثانویه جهت تأیید نتایج مثبت حاصل از محیطهایی مانند Violet Red Bile Lactose agar (VRBL agar) استفاده میشود.
6. آزمایش نمونههای آبی و محیطی: علاوه بر مواد غذایی و خوراک دام، این محیط برای بررسی آلودگی میکروبی آب آشامیدنی و نمونههای محیطی نیز کاربرد دارد.
7. تشخیص فعالیت تخمیری لاکتوز: باکتریهای هدف لاکتوز را تخمیر میکنند و تولید گاز را نشان میدهند، که به شناسایی و تمایز باکتریها کمک میکند.
برای دریافت استعلام قیمت محیط کشت BGB broth مرک کد 1.05454، لطفا با شماره 02192003669 تماس حاصل فرمایید. کارشناسان ما آماده پاسخگویی به سوالات شما هستند.
نکات ایمنی
نکات ایمنی و نگهداری (Safety & Storage)
در ادامه نکات ایمنی استفاده از محیط کشت برلیانت گرین بایل لاکتوز براث مرک (GranuCult® prime BGB broth) برند مرک را مطالعه خواهیم نمود:
ویژگی | توضیحات |
|---|---|
Hazard Statements (بیانیههای مخاطره) | H412 – مضر برای محیط زیست آبزی در درازمدت |
Precautionary Statements (دستورالعملهای پیشگیری) | P273 – جلوگیری از انتشار در محیط زیست، P501 – دفع محتوا/ظرف طبق مقررات محلی |
Hazard Classifications (طبقهبندی مخاطره) | Aquatic Chronic 3 – مخاطره مزمن برای آبزیان |
Storage Class Code (طبقهبندی نگهداری) | 11 – جامدات قابل اشتعال |
WGK | 3 – مواد خطرناک برای آب |
تجهیزات حفاظت فردی | استفاده از دستکش، ماسک و محافظ چشم در هنگام دستکاری، جلوگیری از استنشاق گرد و غبار |
اگر به دنبال محیط کشت BGB broth مرک هستید، نُـوا شیمی همراهی مطمئن در مسیر تامین نیاز های شما خواهد بود. برای سفارش، دریافت مشاوره فنی و آگاهی از شرایط همکاری؛ از طریق شماره 02192003669 با تیم فروش در ارتباط باشید.
سوالات متداول (FAQ)
سوالات متداول درباره محیط کشت BGB broth:
1. BGB broth برای چه نوع میکروارگانیسمهایی استفاده میشود؟
این محیط کشت برای تعیین، غنیسازی و تأیید Escherichia coli و سایر کلنیهای مدفوعی (fecal coliforms) از مواد غذایی، آب و خوراک دام کاربرد دارد.
2. چگونه باید محیط کشت آماده شود؟
محیط به صورت گرانولار است و قبل از استفاده در آب مقطر حل میشود. دقت شود که از حرارت زیاد یا اتوکلاو کردن آن خودداری شود و محلول با دمای مناسب خنک شده و به صورت استریل استفاده شود.
3. آیا این محیط انتخابی است؟
بله، BGB broth انتخابی و حاوی برلیانت گرین و صفرا برای مهار باکتریهای گرم مثبت است و رشد باکتریهای لاکتوز مثبت، مخصوصاً E. coli، را تشویق میکند.
4. شرایط نگهداری BGB broth چیست؟
باید در محیط خشک و محفظه بسته نگهداری شود و دما بین 15–25°C باشد تا از رطوبت و آلودگی جلوگیری شود.
5. چه نکات ایمنی هنگام استفاده باید رعایت شود؟
استفاده از دستکش، ماسک و محافظ چشم ضروری است. همچنین از انتشار محیط کشت به محیط زیست جلوگیری شود، زیرا H412: مضر برای موجودات آبزی در درازمدت است.

هنوز نظری ثبت نشده
اولین نفری باشید که نظر میدهید
ثبت نظر